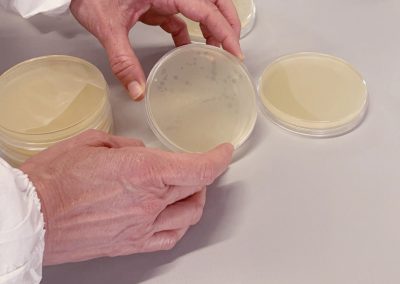

Training
Learn from some of the top microbiologists in the world.
Training
Learn from some of the top microbiologists in the world.
In person training
Looking for some fantastic hands on experience working with our kits and products alongside the guidance and tutelage of those who actually developed the kits?
Come on down to a Bluephage Training Day at the University of Barcelona! An all-day event to gain an intimate understanding of how to use our kits as well as a deep dive into the legislation and regulations behind coliphages.
Online training
Don’t have the time to fully experience our kits or can’t make it to the University of Barcelona?
Fear not, you can still gain a good knowledge and understanding of our kits with a 90-minute training session online with a highly qualified Bluephage professional.